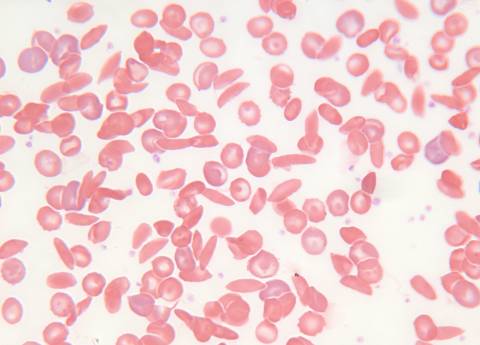
Sickle cell disease seen under the microscope, with different sized red blood cells

You are here
World Sickle Cell Day: Promoting Wellness for Pregnant People with SCD
During her last year of Emory University School of Law, Mimi found herself at a pivotal moment—a final exam that would mark the culmination of years of hard work. But Mimi was not alone in the testing room. She was carrying twins, a pregnancy classified as high-risk given that Mimi lives with sickle cell disease (SCD).
About an hour into the exam, Mimi started to feel some pain. “I'm just going to push this aside and keep writing,” she recalled thinking. As hours passed, she felt increasingly uncomfortable and lightheaded.
“By the end of that exam, the pain was unbearable. I turned in that exam, got myself into my car, and I drove myself straight to the emergency room. I was in so much pain,” Mimi remembered.
Women like Mimi who live with SCD are at higher risk for developing complications during pregnancy than women without the disease. Chief among them are preeclampsia (high blood pressure during pregnancy) and blood clots.
“I was okay. The twins are okay, and I graduated,” says Mimi, who is now a 42-year-old lawyer and mom of four living in Atlanta, GA. “It was a lot of work to try to bear kids as a person with sickle cell. You're constantly in the hospital. You're constantly being monitored, constantly requesting one test after another.” She also had to receive regular blood transfusions during her pregnancy.
It was a lot of work to try to bear kids as a person with sickle cell.
For some women, like Mimi, pregnancy can make their sickle cell disease more severe, and treatments may need to be adjusted to help manage their complications. This makes it especially important for people with SCD to receive regular preconception, prenatal and postpartum care. If you’re living with the disease and are pregnant or thinking about getting pregnant, it’s important to seek out care from a team of healthcare providers you trust and who have experience caring for women with SCD.
There are lots of resources available to help too, including detailed fact sheets with steps to take before, during and after your pregnancy, available in English and Spanish (see the sidebar for links). These materials were developed by CDC in collaboration with the Sickle Cell Reproductive Health Education Directive, the American Society of Hematology and the Foundation for Women & Girls with Blood Disorders.
Learn more about Mimi and others with SCD in the Stories of Sickle Cell video series.